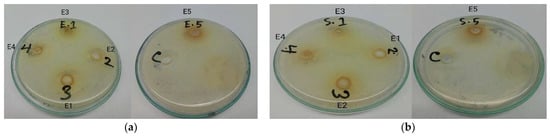

Abstract
The present research work was conducted on developing sustainable production of mulberry filament silk fabric dyed with different extracted dye solutions based on extraction ratios of 1:4, 1:6, 1:8, and 1:10 from neem (Azadirachta indica) leaves. The research work focused on evaluating the antimicrobial and mosquito repellent properties of dyed silk fabric. In the experiment, the samples were dyed using the exhaust method at different dye bath concentrations i.e., 15 g/L, 20 g/L, and 25 g/L in the presence and absence of mordant at 80 °C maintaining 1:60 dyeing liquor ratio. The absorbance of the extracted dye solutions was determined with a UV/VIS spectrophotometer, which detected the highest absorbance of 7.73 at the peak 490 nm of λmax of 1:4 extracted dye solution. Fourier transform infrared (FTIR) spectroscopy was used to investigate the chemical structure of dyed fabrics; however, no chemical changes or bond formation occurred; instead, dye particles were deposited on the fabric layer, indicating the presence of bioactive components. Allergy test was also performed to confirm allergic reactions of neem extract on human skin. The antimicrobial activity of extracted dye solutions and dyed samples was estimated against Gram-positive (Staphylococcus aureus) and Gram-negative (Escherichia coli) bacteria using the agar diffusion method and mosquito repellency of fabrics were examined by the cage method. The results emphasized that dyed fabric with the highest concentrated dye solution, 1:4 extraction, and highest dye bath concentration, 25 g/L along with mango bark mordant solution, possesses the highest antimicrobial activity in terms of an inhibition zone of 0.67 mm against Gram-negative bacteria and 0.53 mm against Gram-positive bacteria obtained after incubation, and the highest mosquito repellent of 75% due to the absorption of active bio constituents. The experimental results also determined that the dyed fabric with 1:4 extracted dye solution exhibited good antimicrobial (inhibition zone, 0.65 mm against E. coli and 0.52 mm against S. aureus) and mosquito repellent property (66.67%). The experimental study also revealed that Potassium dichromate mordant reduced the antimicrobial (inhibition zone, 0.05 mm against E. coli and no inhibition against S. aureus) and mosquito repellent action (33.33%). In conclusion, the data revealed that the increase in the extraction ratio of dye solution and dye bath concentration has no impact on the silk fibroin; it only impacts what is deposited on the fabric layer that improves its antimicrobial and mosquito repellency. The current research showed that neem leaves were found to have a beneficial effect in controlling microorganisms and mosquitoes through a sustainable approach.
1. Introduction
Silk is a fibrous fibroin polymer that reveals a breathtaking selection of fabric from antiquity to the early twenty-first century [1]. Traditionally, silk has been used from royal wardrobes to silk bedding with different brand-new commercial and industrial applications. One modern application of silk is suture materials and medical dressing incorporated into the manufacture of holograms and drug delivery systems [2,3,4]. Silk is hypoallergenic, and thus a suitable choice of fabric for those with asthma, allergies, or sensitive skin, and making it effective in medical textiles. Silk can help people ease their sensitivities, as it naturally wards off some of the world’s most common allergens, such as dust, mites, and mold. Silk is a naturally biodegradable and recyclable material [5]. Synthetic materials cannot be broken down by bacteria alone over time. Consequently, clothing made out of synthetic materials is generally not recyclable or biodegradable [6]. Instead of several commercial species of silkworm larvae, Bombyx mori is widely used for silk farming. Today, silk production is being maintained according to both traditional and newer methods [7]. A total of 192,692.45 metric tonnes of silk were produced worldwide in 2016, representing an increase of 1.26 times over 2012. Silk production in China and India accounted for 97.94 percent of all silk production worldwide in 2016. The value of silk exports in 2016 was USD 2149 Million, which represents a reduction of 31.49 percent from 2012. Among the top silk exporters are China (53.9%), Italy (13.4%), India (4.2%), Romania (4.2%), and France (3.7%), which together total 79.2% of the world’s silk exports [8]. Neem, Azadirachta indica, is regarded as a promising tree species [9], considered a safe medicinal plant that has been used traditionally for centuries [10,11]. Throughout the world, especially in the Indian subcontinent, the neem tree is referred to as a village pharmacy because it cures diseases and is a rich source of antioxidants [12]. Neem displays various medicinal properties such as antioxidant, anti-inflammatory, anticancer, antiviral, antibacterial, antifungal, antiulcer, hepatoprotective, antipyretic, wound healing activities, etc. [13,14,15].
Today, with the increase in awareness of the importance of sustainability, the demand for naturally sourced fibers and dyes in the textile sector has been receiving great attention due to biodegradability and health protection properties, such as microbial and insect resistance [16,17,18]. Silk fiber has a great appeal in clothing for its comfort, hand feel, durability, and aesthetic look, dyed either with synthetic or natural dyes. Silk fiber itself is microbial and insect resistant by nature, while adding natural dyes will enhance the applicability in the medical textile industry. In addition, the neem plant has medicinal value in the Indian subcontinent and tropical countries as a source of therapeutic agents. Previous studies using the neem plant showed that it contains active substances [19] with multiple medicinal properties. Additionally, it has antibacterial properties [20,21] and might be used for controlling airborne bacterial contamination in residential premises. In recent years, dyeing of textile materials with natural dyes is gaining popularity as synthetic dyes are persistent, bio-accumulative, and non-biodegradable. Various studies have been performed in the field of natural dyeing on textiles materials [22,23,24]. A study on enzymatic natural dyeing of cotton and silk fabrics without metal mordants was performed by Padma S. Vankar, et. al. (2007) [25]. A great deal of research has been performed to incorporate the medicinal properties of neem extract as natural dye on textile materials especially cotton and cotton blended fabric. A recent work was found on antimicrobial activity of silk fabric treated with natural dye extract from neem leaves by Abd El Aty et. al. (2018) [26]. They used aqueous neem extract as a natural dye to develop antimicrobial properties of silk fabric. They found that the highest neem dye bath concentration (240 g/L) exhibited good inhibitory effects among different dye bath concentrations (40, 80, 120, 160, 200, and 240 g/L), while using one extracted dye solution from neem leaves. The neem-dyed silk fabrics offered an excellent antibacterial activity against Gram-positive bacteria and Gram-negative bacteria but no inhibitory activities against yeast and fungi were detected. The limitation of the research was that there was no evidence of the influence of mordant and the efficacy of antimicrobial properties after several wash cycles. Another limitation was that they did not show other medicinal properties of neem leaves, especially anti-insect properties, which might show the mosquito repellency of dyed fabric. In view of the fact that neem leaves contain azadiradirachtin, which is effective against in-house flies and is responsible for providing mosquito-repellent properties to neem-dyed fabric, the present study will demonstrate both antibacterial and mosquito-repellency properties using mulberry filament silk fabric dyed with the extracted dye solutions from neem leaves. This study will also show the influence of synthetic and natural mordant on antimicrobial and mosquito-repellent properties.
Therefore, in tropical countries, disease from mosquitoes is one of the greatest problems faced by humans every day. Mosquitoes cause more human suffering than any other organism. In general, mosquitoes are more active around dawn and dusk, although they may also seek hosts during the day. It is possible to avoid being bitten using attractants to attract mosquitoes to other areas, using a repellent, and avoiding actions that may decrease the effectiveness of the repellent. One of the active principle ingredients of natural insecticide is liminoid, such as nimocinolide and isonimocinolide, that is contained in the leaves of the neem plants and is responsible for the bitter test of neem leaves [27]. The neem plant also contains azadiradirachtin, which is effective against in-house flies and when a mosquito consumes this active compound, it destroys its reproductive system. It has been established that neem oil and its leaves extract at an appropriate amount have a repellency power against mosquitoes [28]. Many researchers researched adding a mosquito-repellent finish to textiles, especially to cotton fabric using chemical repellents and natural extraction such as mint, basil, neem plant, etc. [29,30,31,32]. Dhara Shukla, et.al made an experimental work on effective formulation of mosquito repellent from plant sources [33]. A. Gupta and Dr. A Singh did research on the development of mosquito repellent finished cotton fabric using eco-friendly mint and achieved moderate repellency on textile materials [34]. However, there is no research that considered silk fabric for imparting mosquito repellent property.
This study of antimicrobial and mosquito repellency properties of dyed silk fabric with different extracted dye solutions from neem leaves is unique from other researches as no study considered mulberry filament silk fiber as a dyeing material with neem extracted solutions of different absorbance using synthetic and natural mordant as well as evaluating dyed samples’ properties in terms of mosquito repellency and microbial resistance in a single study. A few studies demonstrated natural dyes that are used for textiles, in particular cotton and cotton blended fabric, to evaluate the antimicrobial activity, and found good inhibitory results with coating technology, with a synthetic antibiotic, resin or cross linker involved in achieving antimicrobial properties [35,36]. Furthermore, protein-based fiber silk has better absorbance and wettability [37] than cellulosic fibers and has better dyeing and functional properties [38]. This is the reason, the current study is using mulberry filament silk fabric as textile materials and neem leaves extract as a natural dye to demonstrate the antimicrobial and mosquito repellent properties of the dyed fabrics. A new line of protective medical equipment and dressing materials for wound healing has been opened in the medical sector through this experimental work. Sustainable dyed silk fabric with neem extracts will be a reliable substitute for antimicrobial and mosquito-repellent textile products.
2. Experimental Procedure
2.1. Materials
2.1.1. Fabric
A well-degummed pure mulberry filament silk (7 filament ply per yarn) fabric (Figure 1) was used in the experiment. Degumming of silk involves the subsequent removal of sericin attached to the cleavage of peptide bonds of silk fibroin either by hydrolytic or enzymatic methods [39]. Silk fabric was sourced from Shopura Silk Mill Ltd., Rajshahi, Bangladesh. The ends per inch (EPI), Picks per inch (PPI), Grams per square meter (GSM), and pH of silk fabric was 110, 85, 37, and 7.6, respectively. The CIE whiteness and tint (D65 illuminator, 10 degree observer) of degummed fabric were 42.53% and −2.04.

Figure 1.
Mulberry filament silk fabric.
2.1.2. Dye and Mordant
Neem (Azadirachta indica) leaves were used as a natural dye source for aqueous extraction that was collected from Dhaka, Bangladesh. Synthetic mordant, Potassium dihromate (Brand: MERCK, CAS No. 7778-50-9, Origin: India) was purchased from the local market in Dhaka of Bangladesh and the chemical content of K2Cr2O7 (Assay) was 99% and others were chloride, sulfate, and sodium. A natural mordant, Mango bark solution, was extracted from the bark of the mango (Mangifera indica) plant. A pictorial view of the leaves of neem plant, bark of mango plant and Potassium dichromate is represented in Figure 2.

Figure 2.
Pictorial view of natural dye source and mordant; (a) Dried Neem leaves, (b) dried and powdered Mango bark, and (c) Potassium dichromate.
2.2. Methods
Experimental works used aqueous dye extraction from the leaves of the neem plant and exhaust dyeing of mulberry filament silk fabric to develop properties of antimicrobial and mosquito repellent. To examine the properties of silk fabrics, different characterization methods were performed. A schematic diagram of experimental work is shown in Figure 3. Different characterizing devices were used for experimental procedures. A Lambda 365 UV/Vis spectrophotometer (Brand: Perkin Elmer, Model: 365K7062102, Software version: UV Express-Version 4.1.1 origin: Germany) was used for measuring the absorbance of extracted solutions. A lab IR smart dyeing machine (Brand: Rapid, Origin: Turkey), digital precision balance (Brand: Kern, Model: EW-220-3NM, Capacity: 0.001—220 gm, Origin: Germany), and digital pH meter (Brand: Mettler Toledo 30019029, Model S220 seven compact, Origin: Switzerland,) were used for dyeing experiment. A spectrophotometer (Brand: Data Color, Model: Data color 850, Software: DCI 2:1:1, Origin: Switzerland) was used for analyzing the color strength of dyed samples. Additionally used different color fastness devices such as Crockmaster (Brand: James H. Heal, Origin: United Kingdom), Wascator, or Electrolux (Brand: James H. Heal, Model: 290, Origin: United Kingdom), Perspirometer (Brand: James H. Heal, Origin: United Kingdom), and Xenon Test Chamber (Brand: Q-SUN, Model B02, Origin: USA). Fourier Transform Infrared (FTIR) Spectroscopy (Brand: Perkin Elmer, Model: Spectrum 2, Origin: Germany) was used to identify bioactive materials.

Figure 3.
A schematic diagram of experimental design.
2.2.1. Extraction
The aqueous extraction method was employed for extracting coloring matter from the leaves of the neem plant. To begin with, neem leaves were collected, then washed, cleaned, and dried in sunlight for 24 h to remove moisture from the leaves, and then weighed. Again, the mango bark of the mango plant was collected, cleaned, dehydrated for 10 days in proper sunlight, and powdered. The extracted dye solutions were prepared with different material liquor ratios of 1:4, 1:6, 1:8, and 1:10 whereas dried materials were 30 g each. To facilitate extractions, an electric burner was used to maintain 100 °C temperature by covering the lid for 100 min and simmering for 8 h to cool the extraction and filter the dye solutions. Similarly, mango bark mordant solution was also prepared by aqueous extraction maintaining a 1:30 liquor ratio of 30 g of powdered material (Figure 4). Calculated the pH of the extracted solutions to facilitate the dyeing process as shown in Figure 5. The pH meter was calibrated with pH 4, pH 7, and pH 10 buffer solutions before measuring pH. Every 8-h shift, the pH meter was calibrated in the laboratory. For acidic pH 4, a phosphate buffer was used and for alkaline pH, a 10 ammonium buffer solution was used. For pH 7, a sodium phosphate dibasic dihydrate buffer solution was used. Due to differences in pH and liquor ratios, the color of the extracted solutions varied from dark brown to light brown, represented in Figure 6.

Figure 4.
A schematic diagram of aqueous extraction: (a) dye solutions; (b) mango bark mordant solution.

Figure 5.
pH of extracted solutions.

Figure 6.
Extracted solutions, (a) dye solutions (b) mango bark mordant solution.
2.2.2. Dyeing
Samples of silk fabric were dyed with the extractions individually and also in the presence of mordant (5% owf) through a simultaneous mordanting process in the CHT laboratory in Bangladesh. Samples were dyed using different dye bath concentrations such as 15 g/L, 20 g/L, and 25 g/L with a 1:60 dyeing ratio [40,41] for 60 min at 80 °C for each extraction of 1:4, 1:6, 1:8, and 1:10. The samples and dye bath were prepared and loaded into the dyeing machine at 37 °C with a gradient of 2 °C per minute. After dyeing, samples were rinsed with cold water and squeezed and dewatered. Then samples were dried for 1 min at 100 °C and ironed. A Figure S1 of pictorial view of different dyed samples is given in the supplementary materials.
2.2.3. Sample Labeling
Sample labels were defined according to material composition, type of mordant, dye extraction ratio, and bath concentration during dyeing.
where S stands for silk fiber, K/M stands for the type of mordant (K stands for Potassium dichromate and M stands for extracted Mango bark solution), Ex stands for the dye extraction ratio from neem leaves (E1 for 1:4 extraction, E2 for 1:6 extraction, E3 for 1:8 extraction and E4 for 1:10 extraction), and By stands for bath concentration of dyeing (B1 for 25 g/L dye bath, B2 for 20 g/L dye bath and B3 for 15 g/L dye bath). Examples of a few sample labels for understanding: SE1B1 stands for silk fabric dyed with 1:4 extraction of 25 g/L dye bath concentration, SKE1B1 stands for silk fabric dyed with Potassium dichromate mordant and 1:4 extracted dye solution with 25 g/L dye bath concentration. SME1B1 stands for silk fabric dyed with Mango bark mordant solution and 1:4 extracted dye solution with 25 g/L dye bath concentration. A Table S1 of sample’s identification with sample description is given in supplementary materials.
S K/M ExBy
2.3. Characterization
2.3.1. Ultraviolet-Visible (UV-Vis) Spectrophotometry
Extracted solutions were characterized by assessing absorbance through Lambda 365 UV/VIS spectrophotometer that works on Beer-lambert law (qualitative analysis) [42] whereas absorbance was measured against wavelength of the 200 nm to 800 nm which determine maximum absorbance or optical strength at a particular wavelength of extracted solutions. Additionally, the antimicrobial activity of extracted solutions was assessed following by AATCC TM 147 standard. The antimicrobial was examined against Gram-positive (Staphylococcus aureus) and Gram-negative bacteria (Escherichia coli) in terms of bacteria inhibition zone in millimeter (qualitative analysis).
2.3.2. True-Close Tolerance Spectrophotometer
The K/S value was assessed through Datacolor 850 spectrophotometer by CMC color space and tolerance system to determine color strength of different dyed samples, which works on the Kubelka-Munk formula [43] that shown in Equation (1):
2.3.3. Colorfastness
Different color fastness (C/F) test methods: C/F to rubbing (ISO 105-X12), C/F to wash (ISO 105 C06), C/F to water (ISO 105 E01), C/F to perspiration (ISO 105 E04), and C/F to light (ISO 105 B02) were done to assess fastness properties of dyed samples. Dyed samples of SE1B1, SE2B1, SE3B1, SE4B1, SKE1B1, and SME1B1 were examined to determine colorfastness results.
2.3.4. Antimicrobial Analysis
The antimicrobial property was assessed by AATCC TM 147 standard [44]. Degummed silk fabric, silk samples dyed with the extracted dye solutions (SE1B1, SE1B2, SE2B1, SE2B2, SE3B1, SE3B2, SE4B1, and SE4B2), silk samples dyed with Potassium dichromate and extracted solution from mango bark individually with 1:4 extracted dye solution (SKE1B1, SKE1B2, SME1B1 and SME1B2) were considered to examine of antimicrobial property. The antimicrobial analysis was examined against Gram-positive (Staphylococcus aureus) and Gram-negative (Escherichia coli) bacteria that expressed in terms of the diameter of zone of inhibition in millimeter.
2.3.5. Mosquito Repellency Analysis
The modified cage method according to the WHO standard [45] was considered to examine mosquito repellency property and many researchers followed the modified cage method for obtaining accurate results [46,47,48]. A cage with dimensions of 30 cm × 30 cm × 30 cm (WHO cage standard) was constructed from paper board and plastic materials, as shown in Figure 7. The cage was constructed of paper board, and its top was covered with transparent plastic film. Similarly, a 3 cm square opening was made for mosquitoes and samples to enter the cage. To begin with, we used samples that were 4 cm × 3 cm in size, but the results were not satisfactory. Consider a larger sample size (10 × 5 cm) for testing. The samples were placed in various locations in the cage in order to observe the mosquitoes’ sitting behavior and the cage was shaken two times each at a three-minute interval and three trials were conducted for each test. Samples SE1B1, SE1B2, SE2B1, SE2B2, SE3B1, SE3B2, SE4B1, SE4B2, SKE1B1, SKE1B2, SME1B1, and SME1B2 were considered to examine mosquito repellent properties. Untreated degummed silk fabric was used as a control for evaluating the mosquito repellency percentage of treated samples. The percentage of mosquito repellency was calculated using Equation (2):
where U corresponds to the number of mosquitoes on untreated samples or control samples and T represents the number of mosquitoes on treated samples. This is the regularly used formula as stated by different researchers in their research [49].

Figure 7.
Preparation for cage method, (a) cage (b) collected mosquitoes.
2.3.6. Allergy Test
An allergy test was made to assess the allergic reaction of the dyed sample. To assess the allergic reaction of the dyed sample, we considered three age groups. For assessing itching or rashes, we tested on a small area of the selected person’s skin by wrapping the dyed sample (SE1B1) and then waited for 8 h to observe. If they have a rash, blistering, and swelling in the area or any redness on the skin, then it is considered to be an allergic reaction.
2.3.7. Fourier Transform Infrared Spectroscopy (FT-IR)
FT-IR Spectroscopy was used to identify the characteristic structure of untreated and dyed silk fabric. Dyed Samples of SE1B1 SE2B1, SE3B1, SE4B1, SKE1B1, and SME1B1 were tested to observe chemical changes during dyeing with the extracted solutions of neem leaves. The Scanning area was in the range of 4000–400 cm−1 and data were plotted into the spectrum.
3. Results and Discussions
3.1. Absorbance of Extracted Solutions
Absorbance of extracted solutions were measured against wavelength of 200–700 nm to determined maximum absorbance at a particular wavelength. After analyzing results, highest absorbance of the extracted solutions was found at 300 nm, 370 nm, 430 nm, 490 nm, 510 nm, and 620 nm of the spectrum (Table 1). In the absorbance spectrum, E1 dye solution detected the highest absorbance, 7.73 at the peak of λmax of 490 nm. E2 detected the highest absorbance of 6.21 at the peak of λmax of 430 nm, E3 detected highest absorbance peak of 5.05 at the λmax of 370 nm and E4 detected highest absorbance peak of 5.21 at the λmax of 300 nm represented in Figure 8. Recent research by Abd El Aty et. al. (2018) showed three peaks for absorbance of 3.765, 3.402, and 3.569 at 320 nm, 370 nm, whereas 1:10 material liquor extraction form neem leaves was considered [26]. Optical wavelengths for the green hue in the spectrum range from 300 nm to 520 nm, while optical wavelengths for the green-yellow hue are from 380 to 510 nm. Based on the results of the test, it was determined that E1 extracted solution had the highest absorbance value at 490 nm in comparison to other extracted dye solutions, and that is why dye solution appears green-yellow color when viewed in that region of the spectrum. The maximum absorbance value of E1 extracted solution suggests that this solution would have the highest concentration of dye among the other extracted solutions [50]. In addition, it had less aqueous content during the extraction process. The absorbance spectrum of the extracted mango bark mordant solution, E5 detected three peaks of λmax: the first peak at λmax, 430 nm of absorbance 6.22; the second peak at λmax, 500 nm of absorbance 7.95; the third peak at λmax, 540 nm of absorbance 6.84 displayed in Table 2.

Table 1.
The absorbance of extracted solutions.

Figure 8.
Spectral curve of extracted solutions.

Table 2.
The absorbance of mango bark mordant solution.
3.2. Color Strength
The color strength of an object is related to the reflectance value. The darker shade of samples has a high reflectance value and high K/S value. Test results revealed that the color strength value of dyed samples mordanted with Potassium dichromate, SKE1B1 exhibited the highest color strength value of 13.8. The dyed sample (SE1B1) with 1:4 extracted dye solution showed the highest color strength value of 13.2 among other dyed samples with other extractions. Test results (Table 3) also revealed that the color strength value decreased in the case of dyed samples mordanted with mango bark mordant solution. In tests, samples dyed with most concentrated dye bath with different extracted solutions and mordant exhibited deeper shades and increased K/S values. Thus, in the case of natural dyes, shade development could be improved if concentrated dye baths are used. A Table S2 of color co-ordinate value of dyed samples by spectrophotometer is given in the supplementary materials.

Table 3.
Color strength value (K/S) of dyed samples.
3.3. Colorfastness
All color fastness tests were done in terms of color change and color staining except rubbing fastness and light fastness. The color change under dry rubbing was excellent for all dyed samples compared to wet rubbing. Wet rubbing ratings were only 3 for dyed silk with Potassium dichromate mordant (Table 4). Interestingly, all dyed samples had better water fastness ratings of 4 to 4/5 (Table 5) than Potassium dichromate mordanted sample (SKE1B1) since the Potassium dichromate mordant enhanced the color of neem extractions and produced darker and brighter shades. Additionally, dyed samples demonstrated very good colorfastness to wash greyscale rating (4 to 4/5) displayed in Table 6. In the case of colorfastness to perspiration, all dyed samples had better colorfastness to perspiration in terms of color change (4 to 4/5). In terms of color staining, acid perspiration of dyed samples had better results, as demonstrated in Table 7, than alkali perspiration. Compared to the alkali perspiration (Table 8), all dyed samples had better greyscale ratings of 4 and 4/5 on the greyscale, whereas dyed sample SKE1B1 had poor alkali perspiration based on color staining on the multifiber fabric-acetate, cotton, and polyester had 3/4 and all the other samples had better ratings i.e., 4 and 4/5. The light fastness results of all dyed samples was 4 out of 8 on the wool blue scale, except for dyed silk with Potassium dichromate mordant (3/4 blue scale rating) showed in Table 9. Overall, dyed samples were more colorfast to wash based on the comparison of all fastness test results.

Table 4.
Greyscale rating of color fastness to rubbing.

Table 5.
Color change and color staining rating of color fastness to water.

Table 6.
Color change and color staining rating of color fastness to wash.

Table 7.
Color change and color staining rating of color fastness to acid perspiration.

Table 8.
Color change and color staining rating of color fastness to alkali perspiration.

Table 9.
Blue Scale rating of color fastness to light.
3.4. Antimicrobial Analysis
The dye solutions showed excellent antimicrobial activity, with inhibition zones ranging from 14 to 20 mm for E. coli (Gram-negative bacteria) and 10 to 15 mm for S. aureus (Gram-positive bacteria) on the petri plates (Figure 9). The antimicrobial activity of extracted solutions showed better results against E. coli compared to S. aureus which depended on the activity of active substance (quercetin - a polyphenolic flavonoid) in dye extraction against bacteria. The results demonstrate (Figure 10) that different extracted solutions exhibited different inhibition zones against tested bacteria, depending on the optimization of liquor extractions and dry matter concentration with the extraction medium. The extracted solution, E1 (1:4) had the highest absorbance of 7.73 at 490 nm among other extracted solutions and had the highest antimicrobial activity, i.e., 20 mm inhibition zone against E. coli and 15 mm inhibition zone against S. aureus whereas the extracted solution, E2 had 18 mm inhibition zone against E. coli and 13 mm inhibition zone against S. aureus. Again, E3 and E4 extracted dye solutions had 17 mm and 14 mm inhibition zone against E. coli and 12 mm and 10 mm inhibition zone against S. aureus respectively. A 16 mm inhibition zone was observed against E. coli and a 15 mm inhibition zone was observed against S. aureus in the mordant solution, E5. The test results revealed that extracts from neem leaves showed better activity against Gram-negative bacteria. It could be said that the microbial activity of extracted solution will be dependent on the presence of active bio components and the concentration of extracted solution [51,52].
Figure 9.
Analysis of agar diffusion test in terms of zone of inhibition in mm of extracted dye and mango bark mordant solutions on petri plates against bacteria: (a) Zone of inhibition (mm) against Escherichia coli; (b) Zone of inhibition (mm) against Staphylococcus aureus.

Figure 10.
Bar diagram of antimicrobial test in terms of inhibition diameter of extracted solutions against bacteria of Escherichia coli and Staphylococcus aureus.
Antimicrobial analysis of dyed samples on petri plates after agar diffusion test determined that samples dyed with concentrated dye bath solution with the extracted solution had better inhibition zone against Gram-negative bacteria (Figure 11) and Gram-positive bacteria (Figure 12). Samples dyed with 25 g/L dye bath concentration using different extracted solutions exhibited the diameter of zone of inhibition (ZOI) ranges 0.1 to 0.67 mm against Gram-negative bacteria, E. coli and 0.1 to 0.53 mm against Gram-positive bacteria, S. aureus. It expressed that a layer of neem extract was formed on dyed samples during dyeing that might have present of phytoconstituents alkaloids, flavonoids, glycosides, and saponins considered the antibiotic elements of plant extract [53]. According to test results shown in Table 10, the SE1B1 sample exhibited better diameter of zone of inhibition against bacteria (0.65 mm against E. coli and 0.52 mm against S. aureus). The SE2B1 sample exhibited 0.32 mm ZOI diameter against E. coli and 0.2 mm ZOI diameter against S. aureus. Again, SE1B2 and SE2B2 showed antibacterial activity in terms of diameter of inhibition zone against bacteria that was 0.3 mm and 0.1 mm, respectively against E. coli and 0.15 mm and 0.05 mm against S. aureus. Samples SE3B2 and SE4B2 had no antimicrobial activity against E. coli and Staphylococcus aureus but samples, SE3B1, and SE4B1 had poor antimicrobial activity (ZOI: 0.25 mm and 0.2 mm, respectively, against E. coli and 0.15 mm and 0.1 mm, respectively, against S. aureus).

Figure 11.
Analysis of agar diffusion test in terms of zone of inhibition in mm of degummed and dyed silk fabrics on petri plates against Gram-negative bacteria, Escherichia coli: (a) degummed silk fabric; (b) silk fabric dyed with 1:4 extracted dye solution of 25 g/L dye bath concentration (SE1B1); (c) silk fabric dyed with 1:6 and 1:8 extracted dye solution of 25 g/L dye bath concentration, respectively (SE2B1, SE3B1); (d) silk fabric dyed with 1:10 extracted dye solution of 25 g/L dye bath concentration (SE4B1) and silk fabric dyed with 1:4 dye extraction and Mango bark mordant solution of 25 g/L dye bath concentration (SME1B1) and (e) silk fabric dyed with 1:4 dye extraction and Potassium dichromate of 25 g/L dye bath concentration (SKE1B1).

Figure 12.
Analysis of agar diffusion test in terms of zone of inhibition in mm of degummed and dyed silk fabrics on petri plates against Gram-positive bacteria, Staphylococcus aureus: (a) degummed silk fabric; (b) silk fabric dyed with 1:4 extracted dye solution of 25 g/L dye bath concentration (SE1B1); (c) silk fabric dyed with 1:6 and 1:8 extracted dye solution of 25 g/L dye bath concentration, respectively (SE2B1, SE3B1); (d) silk fabric dyed with 1:10 extracted dye solution of 25 g/L dye bath concentration (SE4B1) and silk fabric dyed with 1:4 dye extraction and Mango bark mordant solution of 25 g/L dye bath concentration (SME1B1) and (e) silk fabric dyed with 1:4 dye extraction and Potassium dichromate of 25 g/L dye bath concentration (SKE1B1).

Table 10.
Diameter of inhibition zone against Escherichia coli and Staphylococcus aureus of dyed fabrics.
In addition, samples dyed with synthetic mordant of Potassium dichromate SKE1B1 showed poor antimicrobial activity against E. coli but had no inhibitory zone against S. aureus. The synthetic mordanted sample, SKE1B2, did not show any inhibition zone against bacteria. It might be said synthetic mordant could destroy or reduce the antimicrobial action of natural extract during dyeing. A naturally mordanted sample, SME1B1, showed highest inhibitory zone among all dyed samples. Samples, SME1B1 and SME1B2 showed 0.67 mm and 0.34 mm inhibition diameter against E coli and 0.53 mm and 0.25 mm inhibition diameter against S. aureus. A natural mordant, Mango bark extracted solution also may contain bioactive agents themselves and influence the antimicrobial action of extracted dye solutions during dyeing [54,55].
3.5. Mosquito Repellency Analysis
This research study focused on repellency against in-house flies (mosquitoes) on dyed silk samples with different concentrated neem (Azadirachta indica) extract along with mordant. The experimental results determined that dyed samples of different extractions have good mosquito repellent percentage ranges 40 to 66.67 % except SE4B2 sample (Table 11). Sample SE1B1 dyed with E1 (1:4) extracted solution showed an excellent mosquito repellency percentage that was 66.67%. Sample SE2B1 dyed with E2 (1:6) extracted solution showed moderate mosquito repellency percentage that was 60% whereas SE3B1 showed 50% mosquito repellency. SE2B2, SE3B2, SE4B1, and SE4B2 samples were showed an average mosquito repellent percentage that was 40%, 40%, 50%, and 25%, respectively. SE1B1 was dyed with the highest concentrated dye solution that is why it gave better repellency (66.67) compared to other samples dyed with E2, E3, and E4 extraction. Moreover, Samples (SME1B1 and SME1B2) dyed with E1 extraction along with Mango bark mordant solution showed the highest repellency (75% and 66.67%, respectively) as natural mordant mango bark contains anti-insecticide compound itself and it increased the antimicrobial and anti-insecticide propertied on dyed sample [56]. However, synthetic mordant Potassium dichromate destroys the antibacterial and anti-insecticide properties on dyed samples. This is the reason that SKE1B1 and SKE1B2 exhibited the lowest mosquito repellent properties. It could be concluded that probably more concentrated dye solution contains more active bio-compound i.e., Azadiradirachtin and provide better repellency power to mosquitoes and this could be understood through the cage test results, such that as soon as tested mosquitoes identify any discomfort and sense lethal a bioactive compound in dyed samples they tried to fly and escape from the tested area, but when they failed to escape from the cage they tried to sit on an untreated area or eventually died on treated samples due to activity of bio-compound [19,57].

Table 11.
Experimental results of mosquito repellent test by cage method.
3.6. Allergy Test Analysis
The experimental result determined that the sample dyed with neem (Azadirachta indica) extract created no allergic reaction on human skin (Table 12). In the research, the sample was treated with plant extracts as a natural repellent agent that is why no allergic reaction occurred.

Table 12.
Experimental allergic test results of the dyed sample, SE1B1.
3.7. FT-IR Test Analysis
In the characteristic pick of silk fabric by FTIR analysis, it is illuminating that untreated degummed silk was identified by four prominent characteristic peaks at 3279.74 cm−1 of 95.51 T% which proved the presence of a strong and broad spectrum of O-H stretching of carboxylic acid usually centered on 3000 cm−1 [58], 1621.89 cm−1 (amide I [59]) of 89.60 T% attributed strong C=C alkene stretching vibrations of the beta-sheet structure of unsaturated ketone [60], 1513.89 cm−1 (Amide II [59]) of 89.17 T% proved N-H bending vibrations and 1228.02 cm−1 of 93.17 T% attributed medium C-N stretching vibrations represent to amide III [61]. Again peaks at around 3343.12 cm−1 are assigned to N-H stretching vibrations and 3071.9 cm−1 C-H aromatic stretching vibrations, 2924.4 cm−1 assigned to medium C-H aliphatic asymmetry stretching alkane vibrations, 2871.85 cm−1 C-H aliphatic symmetry stretching vibrations, 1166.4 attributed to strong C-O stretching tertiary alcohol, and peaks at 500–650 cm−1 assigned to C-C stretching vibration [62]. The FTIR spectrum of the dyed sample was nearly resembling with untreated degummed silk fiber with four prominent peaks [63] demonstrated in Figure 13. It is clearly expressed that there are no chemical changes or bond formations occurring on dyed silk fabric, only dye particles deposited on the fabric layer. If neem extract creates bond or made any chemical changes it would give the characteristic peak of the bond. That is the reason that dyed silk samples were quite similar to untreated silk during FTIR analysis [64,65]. In addition, the experimental report noted that major dye absorption occurred in the amide I and amide II bands and due to the concentration a variety of dye extractions, the band shifted a little (1621.89 to 1622.69 cm−1 and 1512.72 to 1514.44 cm−1), which proved neem dye does not change the characteristics peaks of mulberry filament silk fabric [64,66]. Therefore, bioactive compounds alkaloid isolate has the N-H, C-H, C=C, C=O, C-N, C-O-C group and flavanone and flavonol [67] focus on the heterocyclic ring carbon, and limonoids are highly oxygenated triterpenes as tetranortriterpenoids grouped into glycones and glucosides [68]. Therefore, the presence of the bioactive compounds in the layer dyed samples was proved by FTIR analysis.

Figure 13.
FT-IR spectrum of fabric: (a) degummed silk fabric (untreated); (b) silk fabric dyed with 1:4 extracted dye solution (SE1B1); (c) silk fabric dyed with 1:6 extracted dye solution (SE2B1); (d) silk fabric dyed with 1:8 extracted dye solution (SE3B1); (e) silk fabric dyed with 1:10 extracted dye solution of 25 g/L dye bath concentration (SE4B1); (f) silk fabric dyed with 1:4 extracted dye solution and Potassium di-chromate (SKE1B1). (g) silk fabric dyed with 1:4 extracted dye solution and Mango bark mordant solution (SME1B1).
4. Conclusions
As demonstrated in this study, neem (Azadirachta indica) leaves extract can be used as a potential source of natural dye for silk fabric. Antimicrobial activity and mosquito repellency of dyed mulberry filament silk swatches with neem leaf extracts were investigated. FTIR analysis showed that dyed samples with bioactive components and neem-treated silk fabric did not cause an allergic reaction on human skin, as shown by an allergy test. The experimental results revealed that extracted dye solutions exhibited significant antimicrobial and anti-mosquito activity. Additionally, the dyed samples demonstrated excellent mosquito repellency activity, but moderate activity against bacterial contamination due to the natural origin, and no binding agent was used. Sample, SE1B1 dyed in the presence of concentrated 1:4 extracted dye solution with 7.73 absorbance at 490 nm without mordant had a 0.65 mm zone of inhibition diameter against E. coli and 0.52 mm zone of inhibition diameter against S. aureus and was calculated to have 66.67% mosquito repellency. The sample dyed with natural mordant (SME1B1) exhibited the highest antimicrobial activity (0.67 mm ZOI diameter against E. coli and 0.53 mm ZOI diameter against S. aureus) and excellent mosquito repellent activity (75%) in comparison to dyed samples with extracted dye solutions and synthetic mordant. It could be said that the natural mordant extract itself contains bioactive agents that influence the antimicrobial activity and mosquito-repellent property of the extracted dye solution during dyeing. In contrast, the synthetic mordant somehow destroys or slows down the activity of the extracted dye solution. The inhibition zones indicated that the neem-dyed silk fabrics offered antibacterial activity against E. coli and S. aureus, and the cage test determined excellent mosquito-repellent properties. Further study of this research would be the efficacy of those properties after several wash cycles. Concisely, neem extracts could be an alternative to synthetic anti-mosquito and antibacterial chemicals and could be commercialized in protective textiles.
Supplementary Materials
The following supporting information can be downloaded at: https://www.mdpi.com/article/10.3390/su142215071/s1, Figure S1: Pictorial view of different dyed samples; (a) Degummed silk fabric; (b) Dyed silk fabric with extracted dye solutions from neem leaves; (c) Dyed silk fabric with extracted dye solutions using Potassium dichromate mordant; (d) Dyed silk fabric with extracted dye solutions using Mango bark mordant solution; Table S1: Sample’s identification with sample description; Table S2: Color co-ordinates value of dyed samples.
Author Contributions
Conceptualization, methodology, data analysis and writing, N.J. and Supervision, S.N.A. All authors have read and agreed to the published version of the manuscript.
Funding
There is no funding for this work. It is a part of the M.Sc. research work of Bangladesh University of Textiles (BUTEX).
Institutional Review Board Statement
Not applicable.
Informed Consent Statement
Not applicable.
Data Availability Statement
Not applicable.
Acknowledgments
Heartfelt thanks to ASM Hafizur Rahman, Executive Director, CHT laboratory of RH corporation of Aziz group and Johny Yasmin Kanta, General Manager, Hohenstein Laboratories Bangladesh Ltd. for providing lab facilities for the execution of the research. The authors wish to thank Tahmid Hasan, student of the Department of Environmental Science and Engineering, Bangladesh University of Textiles for drawing the schematic diagrams of this manuscript.
Conflicts of Interest
All authors have declared that there is no conflict of interest with this work.
References
- Datta, R.K.; Nanavaty, M. Global Silk Industry: A Complete Source Book; Universal-Publishers: Irvine, CA, USA, 2005. [Google Scholar]
- Peng, Z.; Yang, X.; Liu, C.; Dong, Z.; Wang, F.; Wang, X.; Hu, W.; Zhang, X.; Zhao, P.; Xia, Q. Structural and mechanical properties of silk from different instars of Bombyx mori. Biomacromolecules 2019, 20, 1203–1216. [Google Scholar] [CrossRef] [PubMed]
- Chen, X.; Hou, D.; Tang, X.; Wang, L. Quantitative physical and handling characteristics of novel antibacterial braided silk suture materials. J. Mech. Behav. Biomed. Mater. 2015, 50, 160–170. [Google Scholar] [CrossRef] [PubMed]
- Alexander, J.W.; Kaplan, J.Z.; Altemeier, W. Role of suture materials in the development of wound infection. Ann. Surg. 1967, 165, 192. [Google Scholar] [CrossRef] [PubMed]
- Zuo, B.; Dai, L.; Wu, Z. Analysis of structure and properties of biodegradable regenerated silk fibroin fibers. J. Mater. Sci. 2006, 41, 3357–3361. [Google Scholar] [CrossRef]
- Andreeßen, C.; Steinbüchel, A. Recent developments in non-biodegradable biopolymers: Precursors, production processes, and future perspectives. Appl. Microbiol. Biotechnol. 2019, 103, 143–157. [Google Scholar] [CrossRef]
- Hashino, T.; Otsuka, K. The rise and fall of industrialization: The case of a silk weaving district in modern Japan. Aust. Econ. Hist. Rev. 2020, 60, 46–72. [Google Scholar] [CrossRef]
- Popescu, A. Considerations upon the trends in the world silk trade. People 2018, 7, 10. [Google Scholar]
- Girish, K.; Shankara, B.S. Neem–a green treasure. Electron. J. Biol. 2008, 4, 102–111. [Google Scholar]
- Conrick, J. Neem: The Ultimate Herb; Lotus Press: Dallas, MI, USA, 2001. [Google Scholar]
- Gowda, M.; Sheetal, A.; Kole, C. The Neem Genome; Springer: Berlin/Heidelberg, Germany, 2019. [Google Scholar]
- Lilot, L.S. The Neem Tree: The Village Pharmacy. Ethnobot. Leafl. 2000, 2000, 9. [Google Scholar]
- Biswas, K.; Chattopadhyay, I.; Banerjee, R.K.; Bandyopadhyay, U. Biological activities and medicinal properties of neem (Azadirachta indica). Curr. Sci. 2002, 82, 1336–1345. [Google Scholar]
- Mahmoud, D.A.; Hassanein, N.M.; Youssef, K.A.; Abou Zeid, M.A. Antifungal activity of different neem leaf extracts and the nimonol against some important human pathogens. Braz. J. Microbiol. 2011, 42, 1007–1016. [Google Scholar] [CrossRef] [PubMed]
- Al-Hashemi, Z.S.S.; Hossain, M.A. Biological activities of different neem leaf crude extracts used locally in Ayurvedic medicine. Pac. Sci. Rev. A Nat. Sci. Eng. 2016, 18, 128–131. [Google Scholar] [CrossRef]
- Teklemedhin, T.; Gopalakrishnan, L. Environmental friendly dyeing of silk fabric with natural dye extracted from Cassia singueana plant. J. Text. Sci. Eng. 2018, 3, 2. [Google Scholar] [CrossRef]
- Saxena, S.; Raja, A. Natural dyes: Sources, chemistry, application and sustainability issues. In Roadmap to Sustainable Textiles and Clothing; Springer: Berlin/Heidelberg, Germany, 2014; pp. 37–80. [Google Scholar]
- Wangatia, L.M.; Tadesse, K.; Moyo, S.; Wangatia, L.M.; Tadesse, K.; Moyo, S. Mango bark mordant for dyeing cotton with natural dye: Fully eco-friendly natural dyeing. Int. J. Text. Sci. 2015, 4, 36–41. [Google Scholar]
- Kumar, R.; Mehta, S.; Pathak, S.R. Bioactive constituents of neem. In Synthesis of Medicinal Agents from Plants; Elsevier: Amsterdam, The Netherlands, 2018; pp. 75–103. [Google Scholar]
- Krishnan, Y.; Wong, N. Cytotoxicity and antimicrobial properties of neem (Azadirachta indica) leaf extracts. Int. J. Pharm. Pharm. Sci. 2015, 7, 179–182. [Google Scholar]
- Susmitha, S.; Vidyamol, K.K.; Ranganayaki, P.; Vijayaragavan, R. Phytochemical extraction and antimicrobial properties of Azadirachta indica (Neem). Glob. J. Pharmacol. 2013, 7, 316–320. [Google Scholar]
- Adeel, S.; Zia, K.M.; Abdullah, M.; Rehman, F.U.; Salman, M.; Zuber, M. Ultrasonic assisted improved extraction and dyeing of mordanted silk fabric using neem bark as source of natural colourant. Nat. Prod. Res. 2019, 33, 2060–2072. [Google Scholar] [CrossRef]
- Zuber, M.; Adeel, S.; Rehman, F.U.; Anjum, F.; Muneer, M.; Abdullah, M.; Zia, K.M. Influence of microwave radiation on dyeing of bio-mordanted silk fabric using neem bark (Azadirachta indica)-based tannin natural dye. J. Nat. Fibers 2019, 17, 1410–1422. [Google Scholar] [CrossRef]
- Sahoo, T.; Dash, S.K.; Das, P. Colouring characteristics of neem (Azadirachta indica) bark dye on silk. Int. J. Agric. Environ. Biotechnol. 2013, 6, 695–702. [Google Scholar] [CrossRef]
- Vankar, P.S.; Shanker, R.; Verma, A. Enzymatic natural dyeing of cotton and silk fabrics without metal mordants. J. Clean. Prod. 2007, 15, 1441–1450. [Google Scholar] [CrossRef]
- Abd El Aty, A.A.; El-Bassyouni, G.T.; Abdel-Zaher, N.A.; Guirguis, O.W. Experimental study on antimicrobial activity of silk fabric treated with natural dye extract from neem (Azadirachta indica) leaves. Fibers Polym. 2018, 19, 1880–1886. [Google Scholar] [CrossRef]
- Tan, Q.-G.; Luo, X.-D. Meliaceous limonoids: Chemistry and biological activities. Chem. Rev. 2011, 111, 7437–7522. [Google Scholar] [CrossRef] [PubMed]
- Jahan, T.; Begum, Z.A.; Sultana, S. Effect of neem oil on some pathogenic bacteria. Bangladesh J. Pharmacol. 2007, 2, 71–72. [Google Scholar] [CrossRef]
- Anuar, A.A.; Yusof, N. Methods of imparting mosquito repellent agents and the assessing mosquito repellency on textile. Fash. Text. 2016, 3, 12. [Google Scholar] [CrossRef]
- Raja, A.S.; Kawlekar, S.; Saxena, S.; Arputharaj, A.; Patil, P.G. Mosquito protective textiles—A review. Int. J. Mosq. Res. 2015, 2, 49–53. [Google Scholar]
- Banupriya, J.; Maheshwari, V. Effects of Mosquito Repellent finishes by Herbal Method on Textiles. Int. J. Pharm. Life Sci. 2013, 4, 3133–3134. [Google Scholar]
- Wannang, N.N.; Ajayi, V.F.; Ior, L.D.; Dapar, L.M.; Okwori, V.A.; Ohemu, T. Mosquito repellant property of Azadirachta indica extract (fruit bark and seed kernel). Sci. Res. J. 2015, 3, 1–4. [Google Scholar]
- Shukla, D.; Wijayapala, S.; Vankar, P.S. Effective mosquito repellent from plant based formulation. Int. J. Mosq. Res. 2018, 5, 19–24. [Google Scholar]
- Gupta, A.; Singh, A. Development of mosquito repellent finished cotton fabric using eco friendly mint. Int. J. Home Sci. 2017, 3, 155–157. [Google Scholar]
- Joshi, M.; Ali, S.W.; Rajendran, S. Antibacterial finishing of polyester/cotton blend fabrics using neem (Azadirachta indica): A natural bioactive agent. J. Appl. Polym. Sci. 2007, 106, 793–800. [Google Scholar] [CrossRef]
- Eid, B.M.; El-Sayed, G.M.; Ibrahim, H.M.; Habib, N.H. Durable antibacterial functionality of cotton/polyester blended fabrics using antibiotic/MONPs composite. Fibers Polym. 2019, 20, 2297–2309. [Google Scholar] [CrossRef]
- Liang, Z.; Zhou, Z.; Li, J.; Zhang, S.; Dong, B.; Zhao, L.; Wu, C.; Yang, H.; Chen, F.; Wang, S. Multi-functional silk fibers/fabrics with a negligible impact on comfortable and wearability properties for fiber bulk. Chem. Eng. J. 2021, 415, 128980. [Google Scholar] [CrossRef]
- Mozumder, S.; Majumder, S. Comparison between cotton and silk fabric dyed with turmeric natural colorant. Daffodil Int. Univ. J. Sci. Technol. 2016, 11, 73. [Google Scholar]
- Sonwalkar, T.N. Handbook of Silk Technology; Taylor & Francis: Abingdon, UK, 1993. [Google Scholar]
- Singhee, D.; Samanta, P. Studies on dyeing process variables for application of Tesu (Butea monosperma) as natural dye on silk fabric. J. Nat. Fibers 2019, 16, 1098–1112. [Google Scholar] [CrossRef]
- Ke, G.; Zhao, Z.; Shuhui, C.; Li, J. Green natural dye from Buddleja officinalis and its ultrasonic dyeing on cotton fabric. Pigment. Resin. Technol. 2021, 51, 110–117. [Google Scholar] [CrossRef]
- Hardesty, J.H.; Attili, B. Spectrophotometry and the Beer-Lambert Law: An important Analytical Technique in Chemistry. Collin College, Department of Chemistry. 2010. Available online: http://vfsilesieux.free.fr/1Seuro/BeerLaw.pdf (accessed on 12 October 2022).
- Yang, L.; Kruse, B. Revised Kubelka–Munk theory. I. Theory and application. JOSA A 2004, 21, 1933–1941. [Google Scholar]
- Pinho, E.; Magalhães, L.; Henriques, M.; Oliveira, R. Antimicrobial activity assessment of textiles: Standard methods comparison. Ann. Microbiol. 2011, 61, 493–498. [Google Scholar] [CrossRef]
- Barnard, D.R.; Bernier, U.R.; Xue, R.; Debboun, M. Standard methods for testing mosquito repellents. In Insect Repellents Principles Methods, Uses; Debboun, M., Frances, S.P., Strickman, D., Eds.; CRC Press: Boca Raton, FL, USA, 2006. [Google Scholar]
- Bano, R. Use of chitosan in mosquito repellent finishing for cotton textiles. J. Text. Sci. Eng. 2014, 4, 1. [Google Scholar]
- Phasomkusolsil, S.; Soonwera, M. Comparative mosquito repellency of essential oils against Aedes aegypti (Linn.), Anopheles dirus (Peyton and Harrison) and Culex quinquefasciatus (Say). Asian Pac. J. Trop. Biomed. 2011, 1, S113–S118. [Google Scholar] [CrossRef]
- Chang, K.S.; Tak, J.H.; Kim, S.I.; Lee, W.J.; Ahn, Y.J. Repellency of Cinnamomum cassia bark compounds and cream containing cassia oil to Aedes aegypti (Diptera: Culicidae) under laboratory and indoor conditions. Pest Manag. Sci. Former. Pestic. Sci. 2006, 62, 1032–1038. [Google Scholar] [CrossRef]
- Patra, A.; Raja, A.; Shah, N. Current developments in (Malaria) mosquito protective methods: A review paper. Int. J. Mosquito Res. 2019, 6, 38–45. [Google Scholar]
- Bukhari, H.; Heba, M.; Khadijah, Q. Eco-friendly dyeing textiles with neem herb for multifunctional fabrics. Part 1: Extraction standardization. Int. J. Tech. Res. App. 2014, 2, 51–55. [Google Scholar]
- Chia, M.A.; Akinsanmi, J.T.; Tanimu, Y.; Ladan, Z. Algicidal effects of aqueous leaf extracts of neem (Azadirachta indica) on Scenedesmus quadricauda (Turp.) de Brébission. Acta Bot. Bras. 2016, 30, 1–8. [Google Scholar] [CrossRef]
- Mohammed, H.A.; al Fadhil, A.O. Antibacterial activity of Azadirachta indica (Neem) leaf extract against bacterial pathogens in Sudan. Afr. J. Med. Sci. 2017, 3, 246–2512. [Google Scholar]
- Win, S.; Ni, K.T. Study on Extraction and Application of Natural Dye from Neem Bark (Melia azadirachta L.). Dagon Univ. Res. J. 2020, 11, 263–269. [Google Scholar]
- Venthodika, A.; Chhikara, N.; Mann, S.; Garg, M.K.; Sofi, S.A.; Panghal, A. Bioactive compounds of Aegle marmelos L.; medicinal values and its food applications: A critical review. Phytother. Res. 2021, 35, 1887–1907. [Google Scholar] [CrossRef]
- Saha, S.; Sadhukhan, P.; Sil, P.C. Mangiferin: A xanthonoid with multipotent anti-inflammatory potential. Biofactors 2016, 42, 459–474. [Google Scholar] [CrossRef]
- Quintana, S.E.; Salas, S.; García-Zapateiro, L.A. Bioactive compounds of mango (Mangifera indica): A review of extraction technologies and chemical constituents. J. Sci. Food Agric. 2021, 101, 6186–6192. [Google Scholar] [CrossRef]
- Sarah, R.; Tabassum, B.; Idrees, N.; Hussain, M.K. Bio-active Compounds Isolated from Neem Tree and Their Applications. In Natural Bio-Active Compounds; Springer: Singapore, 2019; pp. 509–528. [Google Scholar]
- Hemmalakshmi, S.; Priyanga, S.; Devaki, K. Fourier Transform Infra-Red Spectroscopy Analysis of Erythrina variegata L. J. Pharm. Sci. Res. 2017, 9, 2062–2067. [Google Scholar]
- Grdadolnik, J. Saturation effects in FTIR spectroscopy: Intensity of amide I and amide II bands in protein spectra. Acta Chim. Slov. 2003, 50, 777–788. [Google Scholar]
- Ţucureanu, V.; Matei, A.; Avram, A.M. FTIR spectroscopy for carbon family study. Crit. Rev. Anal. Chem. 2016, 46, 502–520. [Google Scholar] [CrossRef] [PubMed]
- Ragavendran, P.; Sophia, D.; Arul Raj, C.; Gopalakrishnan, V.K. Functional group analysis of various extracts of Aerva lanata (L.;) by FTIR spectrum. Pharmacologyonline 2011, 1, 358–364. [Google Scholar]
- Fan, L.; Ziegler, T. Application of density functional theory to infrared absorption intensity calculations on main group molecules. J. Chem. Phys. 1992, 96, 9005–9012. [Google Scholar] [CrossRef]
- Ling, S.; Qi, Z.; Knight, D.P.; Shao, Z.; Chen, X. Synchrotron FTIR microspectroscopy of single natural silk fibers. Biomacromolecules 2011, 12, 3344–3349. [Google Scholar] [CrossRef]
- Boulet-Audet, M.; Lefèvre, T.; Buffeteau, T.; Pézolet, M. Attenuated total reflection infrared spectroscopy: An efficient technique to quantitatively determine the orientation and conformation of proteins in single silk fibers. Appl. Spectrosc. 2008, 62, 956–962. [Google Scholar] [CrossRef]
- Devi, D.; Sarma, N.S.; Talukdar, B.; Chetri, P.; Baruah, K.C.; Dass, N.N. Study of the structure of degummed Antheraea assamensis (muga) silk fibre. J. Text. Inst. 2011, 102, 527–533. [Google Scholar] [CrossRef]
- Kong, X.D.; Cui, F.Z.; Wang, X.M.; Zhang, M.; Zhang, W. Silk fibroin regulated mineralization of hydroxyapatite nanocrystals. J. Cryst. Growth 2004, 270, 197–202. [Google Scholar] [CrossRef]
- Kumar, S.; Pandey, A.K. Chemistry and biological activities of flavonoids: An overview. Sci. World J. 2013, 2013, 162750. [Google Scholar] [CrossRef]
- Tundis, R.; Loizzo, M.R.; Menichini, F. An overview on chemical aspects and potential health benefits of limonoids and their derivatives. Crit. Rev. Food Sci. Nutr. 2014, 54, 225–250. [Google Scholar] [CrossRef]
Publisher’s Note: MDPI stays neutral with regard to jurisdictional claims in published maps and institutional affiliations. |
© 2022 by the authors. Licensee MDPI, Basel, Switzerland. This article is an open access article distributed under the terms and conditions of the Creative Commons Attribution (CC BY) license (https://creativecommons.org/licenses/by/4.0/).